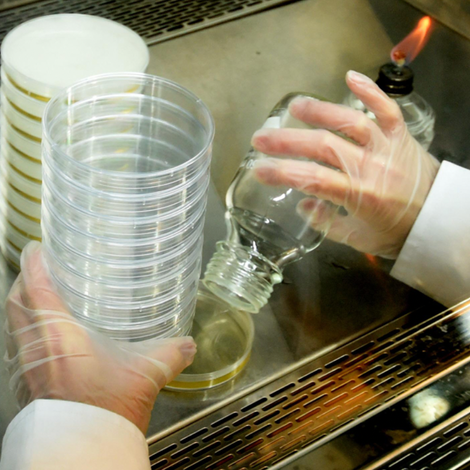

개요
- Mr. Jiang was inspired by his wife in 1965. Where their former home was in Banqiao, they built the New Penglai Food Factory.
- Products include fermented bean curd, red yeast rice sauce, premium fresh chili, and thick bean sauce.
- Main export markets are China, Hong Kong, North America, Oceania, Philippines, and Singapore.
- Products include fermented bean curd, red yeast rice sauce, premium fresh chili, and thick bean sauce.
- Main export markets are China, Hong Kong, North America, Oceania, Philippines, and Singapore.
브랜드 스토리
/seller-story-photo/d4/17/7b/d4177b35a0dd9cfddc4a13126f2a9a8affa80cd9/blob.jpeg)
상품
사진과 동영상
사진

Production
Quality

Quality
추천
XIN-PENG-LAI FOODS CO., LTD.을(를) 추천하고 협력 및 신뢰도 등 해당 회사와의 긍정적인 경험을 공유해 보세요.
추천 수: 0
추천 판매자
'쿠키 허용'을 클릭하면 통계 및 개인 선호도 산출을 위한 쿠키 제공에 동의하게 됩니다.
개인정보 보호정책에서 쿠키에 대한 자세한 내용을 확인할 수 있습니다.
/200x200/company-logo/ef/0b/01/ef0b01b9a2950f3c1524602014ca101021cd3b3b/logo.png)
